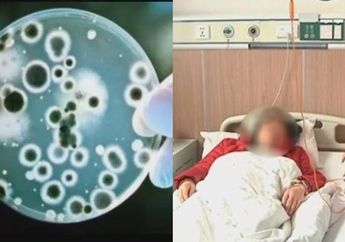
Belajar dari Zhou, Sering Makan Makanan dari Kulkas Ia Justru Terkena Bakteri Langka Mengerikan

1 Tahun yang lalu - Inul Daratista ternyata baru saja jatuh sakit. Inul Daratista diserang bakteri langka yang gejalanya mirip covid. Sang biduan bahkan harus jalani perawatan selama satu bulan lamanya.
5 Tahun yang lalu - Jangan malas jaga kebersihan kulkas. Dengan bahan-bahan sederhana ini, kulkasmu akan jauh dari aroma tidak sedap
6 Tahun yang lalu - Pada 18 Maret lalu, Zhou Ayi datang ke Rumah Sakit Pengobatan Tradisional China dan Barat Tradisional Kota Zhenjiang.
6 Tahun yang lalu - Setelah dilakukan pemeriksaan darah pada 20 Maret, dokter menemukan bahwa ada bakteri langka di darah Zhou Ayi.
8 Tahun yang lalu - Ibu ini hampir kehilangan nyawa karena bakteri pemakan daging, lihat wajahnya yang terserang bakteri tersebut. Mengerikan!